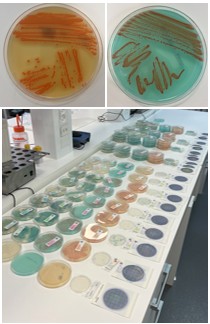

Metodiske problemstillinger indenfor mikrobiologi og kemi
Projektets formål Formålet er at teste og vurdere udvalgte (nye) analysemetoder, vedligeholde gængse analysemetoder, hjemtage viden indenfor mikrobiologiske samt kemiske problemstillinger og formidle denne viden, sammen med testresultater, til den danske kødindustri.
Målet er at teste udvalgte metoder i setupper, der er relaterbare til kødindustrien, hjemtage viden fra relevante fora samt indgå i udvalgte metodeprøvninger

Projektet er støttet af Svineafgiftsfonden og igangsat 1. januar 2025 og forventes afsluttet 31. december 2025.
De forventede direkte resultater vil foreligge i forlængelse af, at de pågældende aktiviteter er gennemført, opgjort og klargjort til offentliggørelse.
Resultaterne offentliggøres på Teknologisk Instituts hjemmeside: Notater og artikler offentliggøres løbende og en slutrapport vil foreligge efter projektets afslutning.
Hvert kvartal offentliggøres en kort status på projekthjemmesiden på Teknologisk Instituts hjemmeside.
Resultaterne stilles gratis til rådighed for alle virksomheder, der er aktive i den pågældende sektor eller delsektor.
Kvartalsrapport 4. kvartal 2025
Det vigtigste nye output er, at det mikrobiologiske laboratorium har afsluttet afprøvning af substrater til kvantificering af Bacillus cereus og vurderet, at flere af de testede substrater udmærker sig ved flot og nem aflæsning (bl.a. BACARA 2, RPC og BC petrifilm). Det mikrobiologiske laboratorium har desuden det håndholdte udstyr ”OPTURA PALM” fra ABER Instruments til afprøvning. OPTURA PALM kan måle celletæthed vha. kontaktløs NIR bioreflektansteknologi og er et alternativ til traditionel manuel spektrofotometrisk OD-måling. Afprøvning og databehandling pågår. Det mikrobiologiske laboratorium har deltaget i ERFA-mødet om mikrobiologiske analyser, hvor temaet var ”Brug og kontrol af trykluft” samt ”Automatisering og AI i det mikrobiologiske laboratorium”. Der blev gennemgået relevante cases og erfaringsudvekslet blandt deltagerne bl.a. om gode erfaringer med problemløsning ved af fund af kontamineret trykluft. EFSA’s årlige rapport over årsager til fødevarebårne sygdomsudbrud udkom 09.12.25 (oversigt for 2024). På europæisk plan er Campylobacter årsag til flest udbrud efterfulgt af Salmonella. E. coli (STEC) indtog 3. pladsen, Listeria monocytogenes 4. pladsen og Ekinokokkose 5. pladsen. Human ekinokokkose er sjælden og skyldes infektion af en bændelormlarve fra slægten Echinococcus (typisk fra hunde og ræve). Årsag til smitte kan fx være bær og svampe inficeret med afføring fra smittede ræve. |
Den næste store aktivitet i projektet er, at igangværende forsøg med afprøvning af OPTURA PALM afsluttes og rapporteres, ligesom 2 årsrapporter fra hhv. det mikrobiologiske og det kemiske laboratorium færdiggøres. Projektet afsluttes ved udgangen af 2025. |

Kvartalsrapport 3. kvartal 2025
Det vigtigste nye output er, at det mikrobiologiske laboratorium i september har deltaget i netværksmøde i ERFA-gruppen ”MikroERFA” om mikrobiologiske analyser og problemstillinger i fødevare-laboratorier. Mødetemaet var i) ”Automatisering og AI i det mikrobiologiske laboratorier” med 3 indlæg fra Mikrolab Frisenette, Århus Universitet og Ngin samt ii) ”Trykluft og fødevarer/pharma – Udfordringer ved brug af trykluft, og hvordan det overvåges” med indlæg fra Michael Pedersen (Eurofins). Der blev gennemgået relevante cases om AI, mulige kontamineringsveje ved trykluft samt erfaringsudvekslet blandt deltagerne bl.a. om problematiske mikrobiologiske analyser og falsk negative resultater. Derudover har det mikrobiologiske laboratorium gennemført sammenligningstest af 6 forskellige kommercielt tilgængelige kvantitative analyser for Bacillus spp./Bacillus cereus (se fotos). Metoderne er testet overfor renkulturer af Bacillus samt spikede fødevare-matricer. Flere substrater udmærkede sig ved at være brugervenlige ift. aflæsning af typiske kolonier. Årets danske zoonose-rapport (2024) fra DTU Fødevareinstituttet er publiceret og der er i 2024 set et fald i antallet af udbrud fra 64 (2023) til 55 (2024) udbrud, hvilket primært skyldes et fald i antallet af Salmonella udbrud. Begge laboratorier (kemisk og mikrobiologisk) har fået fornyet DANAK-akkreditering ved audit. Det kemiske laboratorium har deltaget i ringtest for kødprøver ved FAPAS. Der er foretaget en undersøgelse af alternativer til spektrofotometer for måling af laktat og acetat i kødprøver. |
Den næste store aktivitet i projektet er, at opnåede data fra sammenligningstest af 6 kommercielt tilgængelige mikrobiologiske analyser for Bacillus skal analyseres og sammenfattes i en rapport. Desuden skal rapport om toksiner i fødevarer afsluttes. Indledende forsøg med laktat og acetat på HPLC. |
Kvartalsrapport 2. kvartal 2025
Det vigtigste nye output er, at: I det kemiske laboratorium har der været fokuseret på hjemtagning af viden om metoder til analyse for mikrobielt dannede toksiner. Konkret er det LC-MS/MS- og ELISA-metoderne, der arbejdes med, dels fordi metoderne er anerkendte til formålet, dels fordi de er meget forskellige og derfor dækker forskellige toksiner. Til opretholdelse af akkrediteringen er der gennemført den årlige interne audit. Endelig er der i det løbende arbejde med optimering af eksisterende metoder udviklet, implementeret og valideret en forbedret dataanalyse ved brug af AI. Dette arbejde er endvidere udgivet som en historie i nyhedsbrev udsendt i juni 2025. Det mikrobiologiske laboratorium har haft besøg af danske og udenlandske leverandører af analyser og udstyr, og der er bl.a. indhentet information om automatiseringsløsninger til laboratorier i form af robotter til dispensering i både flasker, rør og mikrotitter-bakker. NMKL har pr. 20. marts 2025 publiceret en opdateret version af NMKL 71 (Ed. 6, 2025) ”Salmonella. Detection in foods”. Metoden erstatter Ed. 5 fra 1999 og har primært gennemgået redaktionelle opdateringer samt harmonisering med NMKL 187 (”Salmonella. Detection in foods, animal faeces and environmental materials from primary animal production using MSRV”, 2018). |
Den næste store aktivitet i projektet er, at •Der fortsættes med indkøring af matricestandarder til kemiske analyser – en standard baseret på luncheon meat og en standard målrettet hybridprodukter (kød og planter). •Der fortsættes med indsamling af viden om hurtigmetoder til analyse for patogene mikroorganismer. •Der igangsættes sammenligningstest af flere forskellige kommercielt tilgængelige kvantitative analyser for Bacillus spp./Bacillus cereus. |
Kvartalsrapport 1. kvartal 2025
Det vigtigste nye output er, at der i det kemiske laboratorium er fremstillet to matricestandarder til kemisk analysearbejde af hhv. kød, kødprodukter og hybridprodukter. Den ene standard er baseret på luncheon-meat og anvendes til klassiske metoder som f.eks. vand, fedt, protein, kollagen og salt. Den anden standard kan anvendes til hybridprodukter indeholdende forskellige grøntsager, frugter, fibre og konserveringsmidler. Desuden er der opdateret metoder til dokumentation for at forbedre sporbarheden til de analyser, som er blevet mere efterspurgte til karakterisering af hybridprodukter i branchesamarbejdsprojekterne. Det mikrobiologiske laboratorium har i januar deltaget i netværksmøde i en ny (2024) ERFA gruppe ”MikroERFA” om mikrobiologiske analyser og problemstillinger i fødevare-laboratorier. Mødetemaet var ”Automatisering i laboratorier; muligheder og brug af AI” med indlæg fra Jakob Hartvig Stiesmark (Teknologisk Institut) og ”Biosikring, regler og implementering” med indlæg fra Center for Biosikring og Bioberedskab, CBB (3 oplægsholdere). Der blev gennemgået relevante cases om AI, lovkrav mhp. biosikring samt erfaringsudvekslet blandt deltagerne bl.a. om opnåede resultater ved automatiserings- og effektiviseringstiltag i laboratorierne. Zoonoserapport fra EFSA for 2023 omhandler europæiske fødevare-relaterede sygdomsudbrud i 38 lande. Top 5 mikroorganismer, som var årsag til sygdoms-udbruddene var: 1) Campylobacter, 2) Salmonella, 3) E.coli (STEC), 4) Yersinia enterocolitica, 5) Listeria monocytogenes. Infektioner forårsaget af Listeria monocytogenes (sammen med West Nile virus infektioner) resulterede i de mest alvorlige zoonotiske sygdomme med den højeste procentdel af hospitalsindlæggelser og den højeste dødelighed blandt tilfældene. |
| Den næste store aktivitet i projektet er, at der i det mikrobiologiske laboratorium indsamles viden om mikrobiologiske hurtigmetoder til udvalgte mikroorganismer, mens der i det kemiske laboratorium arbejdes videre med indkøring af matricestandard (til hybridprodukter) i en række analysemetoder. |